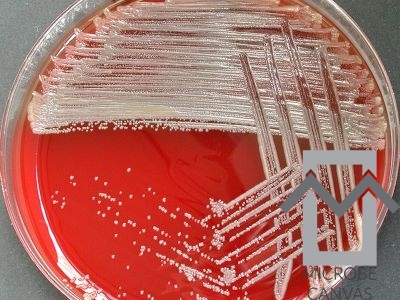
brevundimonas-vesicularis_nf28_bewaarvl_ba_48-2_f-400x300__wm__ brevundimonas

Case Report
Brevundimonas vesicularis is a member of the Alphaproteobacteria class and the Caulobacteraceae family. It was formerly classified as Pseudomonas vesicularis but was later reclassified into the new genus “Brevundimonas” by Segers et al. in 1994. It is an aerobic, non-lactose, oxidase- and catalase-positive, flagellated Gram-negative rod. The organism can be isolated in a laboratory using blood or chocolate agar. But not all strains thrive on MacConkey agar.
It is an opportunistic pathogen that can cause septicemia, pneumonia, meningitis, septic arthritis, urinary tract infections in children, and cervicitis in women. It primarily affects people with underlying medical disorders such congenital heart disease, respiratory distress syndrome, various congenital brain defects, and meconium aspiration syndrome.
Patients with foreign bodies and immunocompromised persons are at verge but rarely those without a predisposing illness. Many of these infections were due to hospital admissions or in the community.
B. vesicularis is an emerging global opportunistic pathogen of concern. A case series of B. vesicularis infections in the neonatal period at a tertiary health facility in Turkey found that four of the eight patients had congenital heart disease, two had respiratory distress syndrome, multiple congenital cerebral anomalies, and meconium aspiration syndrome. All eight instances had septicaemia.
Healthcare infrastructure in rural Gambia and other resource-constrained areas is frequently insufficient, limiting access to diagnostic instruments and appropriate treatments. B. vesicularis infections can exacerbate pre-existing health concerns, such as malnutrition and co-infections with other pathogens, leading to greater morbidity and mortality rates in these settings. The rise of opportunistic infections like B. vesicularis in vulnerable populations emphasizes the need for improved surveillance and healthcare measures.
These infections reflect larger global health issues, such as access to healthcare. Recognizing and managing the impact of B. vesicularis infections in resource-constrained settings is critical for improving public health and reducing health disparities worldwide.
This is a case of B. vesicularis sepsis in a 2-month-old child with cyanotic congenital heart disease at a rural Gambia hospital.
Case Presentation
The mother brought in a 2-month-old African male newborn after experiencing a 2-week history of nonparoxysmal cough, rapid breathing, and lower-chest-wall indrawing. There was fever, along with extreme agitation at first but then unresponsiveness. The respiratory distress intensified while feeding, and the mother observed the child’s lips had turned blue. There was no history of choking on food, vomiting, or diarrhea. There had been no history of forced feeding or administering herbal concoctions to the infant. The mother also noted that the child had not acquired any significant body weight since birth.
The pregnancy was planned and proceeded without difficulties, with the mother routinely attending antenatal care (ANC) sessions. It was a single-fetus pregnancy, and the baby was born full-term. The mother had no significant medical history. She obtained the recommended prenatal tetanus toxoid immunization, and her HIV screening result was negative. There were no maternal risk factors, thus she had a spontaneous vaginal delivery in the hospital.
The newborn weighed 3 kg was in stable health immediately after birth. Both the mother and the infant discharged on the day of delivery.
Physical examination revealed an exceedingly ill-looking, sluggish newborn with a fever of 35.10 °C, respiratory distress, and central cyanosis. He was, however, anicteric, not pallid, and well-hydrated. The capillary refill time was two seconds.
The respiration rate was 65 breaths/minute. Auscultation revealed considerable chest retraction and bronchial breath sounds, with oxygen saturation of < 85%. Percussion reverberated through the chest. The heart rate was 140 beats per minute, with a persistent murmur in the sternum. Other systemic exams were ordinary.
Investigation
Sepsis was diagnosed with cyanotic congenital heart disease, with pneumonia as a possible differential diagnosis. A complete blood count, electrolyte assay, chest X-ray, and echocardiogram showed hemoglobin was 13.2 g/dl, the malaria RDT was negative, and the random blood sugar level was 4.1 mmol/l.
The blood sample cultured on various agar plates, revealed yellow-colored colony growth. Gram-negative short oxidase-positive rods isolated, and Brevundimonas vesiculari was identified. Antibiotic sensitivity assessed using Kirby-Bauer disk diffusion method, and the bacterium had sensitivity to all tested antibiotics.
Progress
After 48 hours of hospitalization, the body temperature ranged between 36.70 and 38.50 °C. The infant was adequately hydrated, and his oxygen saturation level had increased to 92%. The child was still experiencing respiratory difficulty. Based on the culture and sensitivity results, as well as the child’s improved condition, we maintained the IV antibiotics. After 72 hours of treatment, the body temperature ranged between 36.50 and 37.20 degrees Celsius. While on oxygen, the oxygen saturation ranged from 88% to 92%.
The fever disappeared six days post admission to the hospital. The central nervous system examination demonstrated enhanced consciousness, and the kid was alert and fed (expressed breast milk [EBM]) with a cup and spoon. A repeat blood culture revealed no bacterial development. We then referred the child to the teaching hospital for an echocardiography and a cardiologist evaluation.